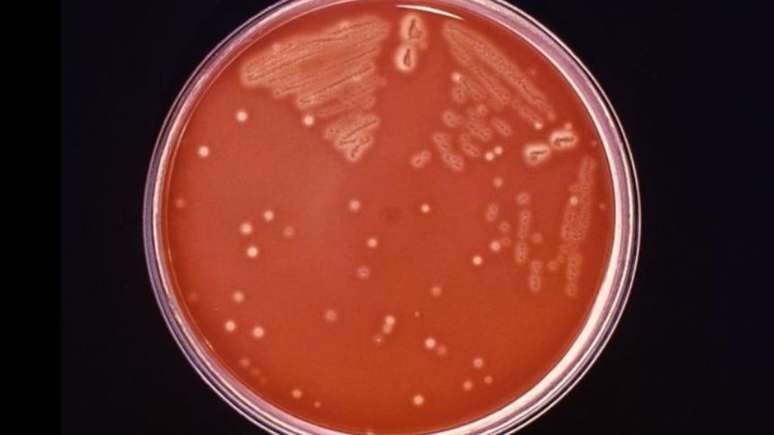

O que se sabe sobre infecção por bactéria carnívora rara que matou três pessoas nos EUA?
As vítimas tinham entre 60 e 80 anos e morreram após nadar em locais infectados com 'Vibrio vulnificus'
Pelo menos três pessoas morreram nos Estados Unidos após contrair infecção grave causada por uma bactéria carnívora rara. Segundo autoridades sanitárias, esta bactéria pode ser encontrada em águas quentes e salobras ou em mariscos crus nos estados de Nova York e Connecticut. De acordo com autoridades, as vítimas tinham entre 60 e 80 anos.
Em Connecticut, duas pessoas foram infectadas com Vibrio vulnificus e morreram depois de nadar em dois locais separados em Long Island Sound. Uma terceira pessoa foi infectada em julho após se alimentar de ostras cruas de um estabelecimento fora do estado. Autoridades estão aconselhando as pessoas a tomarem precauções antes de consumir ostras cruas ou serem expostas a água salgada ou salobra.
Mueren tres personas por una infección con una rara bacteria carnívora en Connecticut y Nueva York https://t.co/1pmDY7bfjR
— CNN en Español (@CNNEE) August 17, 2023
Sobre a bactéria carnívora
De acordo com os Centros de Controle e Prevenção de Doenças dos EUA, "Vibrio vulnificus" causa cerca de 80.000 doenças e 100 mortes nos Estados Unidos todos os anos. Ela é da mesma família da bactéria que causa a cólera.
Em casos leves, a infecção bacteriana pode causar feridas na pele, bolhas, abscessos e úlceras. Os sintomas são: calafrios, febre, diarreia, dor de estômago e possivelmente vômitos.
"As pessoas devem considerar o risco potencial de consumir ostras cruas e exposição à água salgada ou salobra e tomar as devidas precauções", disseram autoridades do Departamento de Saúde Pública em comunicado à imprensa sobre os cuidados em relação à bactéria carnívora.

-ubrh7vzfaqub.png)





